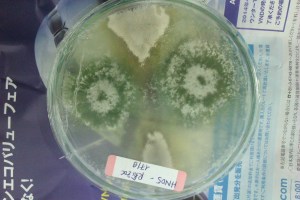
Soil fungi, blocking the growth of a pathogen. Vietnam 2014.

Date: February 19, 2015
Description:
Soil fertility is a function of the wide range of organisms living in the soil, such as earthworms, nematodes, protozoa, fungi, bacteria and arthropods. They all work together to decompose organic matter, solubilize minerals from rocks and form complex molecules and humus. Humus is the base of life again as it forms soil structure, acts as nutrient bank and forms a nurturing ecosystem for plants to grow healthy. Soil biology studies this complex ecosystem and the ecological functions that it performs.
Soil moisture supports this microbial activity within the soil, which means that water harvesting and moisture management greatly affect soil fertility.
In this webinar, Ruben Borge discusses the basic principles and emerging concepts of soil biology relevant to agriculture. He also draws some relations to water harvesting, and their potential effects on soil life.
